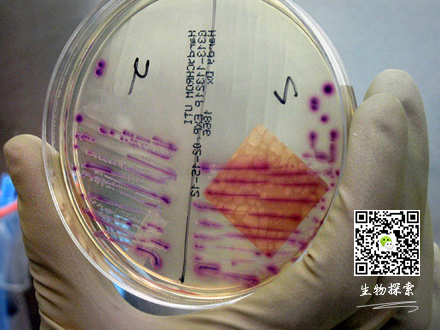

兰斯•普赖斯(Lance Price)是乔治•华盛顿大学(George Washington University)的一名微生物学家。在一年期间,他每月两次让他的研究人员从美国亚利桑那州弗拉格斯塔夫市的各个主要的副食品商店里购买所有品牌的鸡肉、火鸡肉和猪肉。当科学家们推着满载肉食的推车走过过道时,不时有好奇的顾客询问他们是否正在尝试阿特金斯饮食法(Atkins diet)。
引发尿路感染
事实上,普赖斯教授和他的研究团队此举旨在就抗生素耐药菌从工业化农场饲养的动物向人类的传播,为一系列令人担忧的问题寻求答案。具体而言,他们试图计算出在一个美国城市中,有多少人会因副食品商店出售的肉类而发生尿路感染。
普赖斯教授经常戏称自己是某种囤积癖患者。他自己的冰柜就像是个样本大杂烩,塞满了人类鼻窦和内耳的拭子样本,甚至还有水烟管中水的样本。但是,在他位于弗拉格斯塔夫市的非营利性研究机构的冰柜里,整整齐齐地排列着成千上万个容器,其上标有识别条码,内里则分别装着从该市收集的肉类制成的肉汁。
普赖斯教授雄心勃勃,他试图借助现代基因测序的力量,将肉类中的病菌与患尿路感染的女性体内的病菌精确地匹配起来。最近的一天,他在华盛顿他的大学办公室里研究其中某些肉类中的病菌的谱系树。这些图谱打印出来超过了25页,像卷纸一样铺了一地,以至他不得不手足并用地趴在地上。普赖斯教授期望这些图谱上的线条和数字能为他所关心的核心问题提供早期线索:在弗拉格斯塔夫市,有多少女性因副食品商店的肉类而发生尿路感染?他预计初步的答案能在今年秋天揭晓。
可耐多种抗生素的细菌
多年来,研究人员一直在警示人们,抗生素这一在20世纪改变了人类健康进程的神奇药物正逐渐失去它们的魔力。有人警告说,如果不对这种趋势加以遏止,人类很有可能会再度堕入普通感染足以致人死地,而区区脓毒性咽喉炎将夺去儿童生命的黑暗时代。目前,每年因耐药性细菌导致的死亡达10万例左右,但其中大多数是免疫力低下的患者、儿童和老年人。
关于滥用抗生素引起耐药性日渐增加这一点,人们已达成了广泛的共识。科学家们纷纷表示,有越来越多的证据显示,在农场里大量使用抗生素来促进动物生长是一大罪魁祸首,该行为给耐药菌提供了储主,使得这些病菌得以无孔不入地蔓延至人类社区。美国使用的所有抗生素中,有70%以上都用于动物。
农业集团并不同意这一指控,他们认为人类过度使用抗生素治疗才是最主要的问题,并辩称,病菌很少从动物传染给人类,且即使真的发生这种情况,它们对人类健康造成的风险也可以忽略不计。
科学家们表示,基因测序将为这场辩论带来更大的确定性。在该技术的帮助下,他们将能够跟踪人体内病菌的起源,并追溯它们究竟是来自农场的养殖动物还是来自医院里的其他患者。来自纽约的民主党众议员路易丝•斯劳特(Louise Slaughter)一直致力于推动立法来控制农场中的抗生素使用,她也相信这类确凿的证据应足以解决争议。
普赖斯教授一直在寻求一种方法,用以量化动物中的耐药性病菌感染人类的广泛程度。去年,他从弗拉格斯塔夫市副食品商店出售的肉类中和该市人群体内均收集了病菌样本,并尝试通过分析这两类样本的全基因组成来达成他的目标。随着基因组测序成本的直线下降,他的研究构想正逐步实现。
他从肉类样本中发现了耐多种抗生素的耐药性大肠杆菌,并将其与导致人类(大多数为女性)尿路感染的细菌进行了基因序列比较。
科学家们选择泌尿系统感染作为研究对象的原因在于这种疾病非常普遍。在美国,每年约有800万以上女性罹患此病。在罕见病例中,感染还可进入血液,造成致命危险。
虽然人们认为,此类感染中仅有一小部分是肉类中的耐药性细菌所导致,但即使如此,其年感染人数也可达数十万。普赖斯教授选择的这一种大肠杆菌可能具有致命性,如果它们出现了抗生素耐药性倾向,势必将更加危险。
当人们食用含有这些病菌的肉类时就会发生感染。病菌在肠道内生长,然后进入尿道。普赖斯博士称,这些病菌也可能通过其他方式,如切割生肉时的割伤等导致感染。由于它们可以自由杂交,因此一旦进入人体,很容易发生变异,并在人与人之间传播。例如2003年,人们在荷兰首次在人体内检出了一种新型抗生素耐药性MRSA菌株,而今,据荷兰研究人员扬•克鲁曼斯(Jan Kluytmans)称,该菌株在该国的人类MRSA感染中所占的比例已达40%。科学家们还指出,在人体内发现该菌株之前,它在农场猪中十分常见。现年44岁的普赖斯博士早在20世纪90年代就开始了他的职业生涯,在生物防御研究中对炭疽的环丙沙星(Cipro)抗生素耐药性进行测试。21世纪初,对公共卫生领域的兴趣引导他踏足抗生素耐药性研究,因为这对人类而言似乎是更加实际的威胁。
一线抗生素不再能治愈基本的感染,这让医生们忧心忡忡。“我想:‘哇,这糟透了,我必须为此做点什么,’ ”他说。他在一家成立于2002年的非营利机构,位于凤凰城的翻译基因组学研究院(Translational Genomics Research Institute)完成了关于抗生素的研究。他在弗拉格斯塔夫市的实验室是该院的附属机构,主要的资助来源于联邦政府,包括美国国立卫生研究院(National Institutes of Health)和国防部(Defense Department)等。
普赖斯博士接受过流行病学和微生物学的严格培训,数年来他一直就抗生素耐药性向人们敲响警钟。最近,他告知国会委员会,有压倒性的证据表明了农场养殖业中抗生素的不良影响。
他认为,美国食品和药品管理局(Food and Drug Administration)在限制农场抗生素使用方面的工作一直较为薄弱。1977年,食品和药品管理局曾表示它将开始禁止抗生素的某些农业用途。但是,以农业利益集团为主导的参众两院拨款委员会(House and Senate appropriations committees)通过了反对该禁令的决议,该机构只好鸣金收兵。最近,该机构已对两类重要的抗生素在动物中的使用施加了限制。但倡导者们称,仍需要更进一步,全面禁止所有用于促进生长的抗生素。目前,瑞典和丹麦都已经推行了上述举措。
斯劳特女士指出,农业企业利益集团的积极游说在阻挠立法通过的过程中发挥了重要作用。据她的工作人员称,在上届国会上,针对她撰写的一项有关抗生素使用的法案,共计提出了225篇游说性披露报告,其中近九成是由反对立法的组织所提交。
但目前所面临的最大障碍可能在于食品经济学。在大规模的工业化农场中,动物们均以密集型方式饲养,彼此之间密切接触,充斥着细菌的粪便和尿液也随处可见。抗生素一方面遏制了感染,但在另一方面又造成了耐药性。就是在这些农场中,出产着美国人日常食用的大量廉价肉类。
政府现已开始认识到这一危险。近期,美国承诺向大型制药公司葛兰素史克(GlaxoSmithKline)提供4000万美元的资助,帮助它开发可克服抗生素耐药性的药物。但普赖斯博士称,新药无法解决所有的问题。
“有很多人说:‘让我们通过创新来走出困境’,”他说,“但是,如果我们不能好好处理我们滥用抗生素的方式,那我们只不过是在拖延时间,最终仍然会走向不可避免的结局。”
